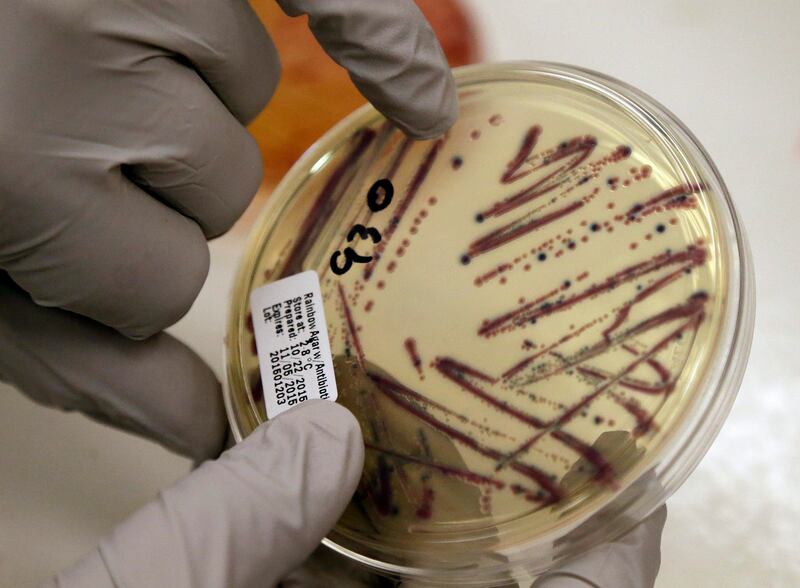

Nine people have been hospitalized and another 20 became sick as a result of what the Centers for Disease Control and Prevention calls a “fast-moving” E. coli outbreak in Michigan and Ohio.
No one has died as a result of the bacterial outbreak, but the source has not been identified, which is cause for concern, according to the CDC’s investigation notice. The agency is asking for help to determine the food source and says those who have symptoms should write down what they ate in the week before becoming ill and report the illness to their local or state health department.
The first illness in the outbreak began on July 26, while the last reported case started Aug. 6. There are 15 people in Michigan and 14 in Ohio who are part of the outbreak.
According to The Washington Post, “In a separate news release, Michigan’s health department said it had received 98 reports of E. coli cases this month — up from 20 in August last year. Natasha Bagdasarian, the chief medical executive at the department, said the ‘significant jump in cases is alarming.’ The Ohio Department of Health said it is assisting federal and local health officials with investigations. The affected individuals range from age 11 to 72, it said.”
According to the CDC, symptoms of E. coli include severe stomach cramps, diarrhea (which may be bloody) and vomiting. The cases were linked by health officials using DNA of E. coli samples. Since the strains appear to be very similar, it’s likely they came from the same food source, the agency said.
The CDC says most people recover on their own within a week, but symptoms that require immediate medical attention include diarrhea and a high fever, diarrhea that is bloody or lasts longer than three days, inability to keep liquids down and signs of dehydration.
Those most at risk from the E. coli are children younger than 5 and those 65 and older, as well as people with weakened immune systems. They are more apt than others to experience severe illness.
The CDC says about 265,000 people a year suffer from E. coli contamination, often linked to poor restroom hygiene by a food preparer or product contamination from animals, as the bacteria live in the intestines of many animals. About 30 people die from E. coli annually, and about 3,600 are hospitalized. Past outbreaks have been linked to eating establishments and to products like salad mixes and garden produce, among others.
It can take several days after exposure to E. coli to become ill, which makes tracking an outbreak more tricky.
The CDC says the best way to avoid E. coli is safe food preparation habits:
- Wash your hands, utensils and surfaces often, including rinsing fruits and vegetables under running water before preparing or eating.
- If the food won’t be cooked, keep it away from raw poultry, meat and seafood.
- Make sure food is cooked thoroughly and check temperatures with a thermometer.
- Chill food that is perishable within two hours. If the weather’s hot, chill within an hour. Thaw food in the fridge, not by leaving it out.